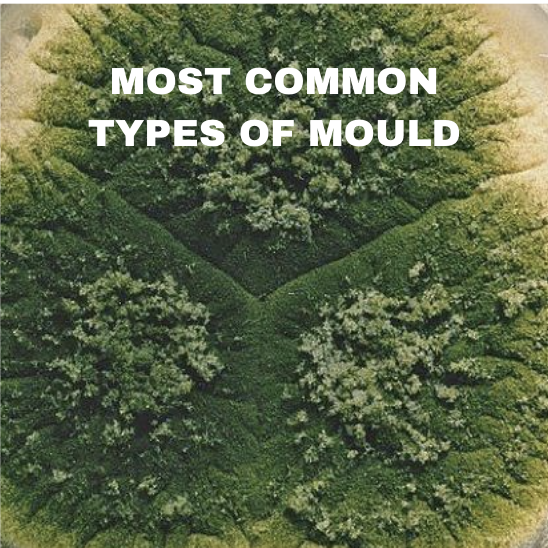

-
 ORDER YOUR KIT
Start your mould testing journey with our 1, 2 or 3 room Starter Kit.
ORDER YOUR KIT
Start your mould testing journey with our 1, 2 or 3 room Starter Kit. -
 TEST YOUR AIR QUALITY
Collect air samples in minutes. It’s that simple.
TEST YOUR AIR QUALITY
Collect air samples in minutes. It’s that simple. -
 GET YOUR AI MOULD TEST RESULTS
Return your pre-paid return box to our lab. Personalised AI results in 2-3 working days from when samples arrive to our mould lab.
GET YOUR AI MOULD TEST RESULTS
Return your pre-paid return box to our lab. Personalised AI results in 2-3 working days from when samples arrive to our mould lab.
An Interview with Mirth Eckl
Mirthe Eckl helps high-performing individuals optimise their health and longevity through a precise, data-driven, root-cause approach.

“Once I implemented what I found, my Crohn's went into remission (and has remained so since 2010!). This led me to pursue a postgraduate qualification in Functional Medicine, which sits at the intersection of conventional medicine, naturopathic medicine, nutrition, and the latest research, with the focus on identifying the root cause of illness rather than suppressing symptoms. "
What will I see in my home mould test?
Our AI home mould testing report identifies nearly 100 different types of mould and airborne pathogens, allowing you to make informeddecisions about how to resolve any issues that our report details, including how to change your home cleaning routines to minimise future risks. You can read about how to interpret your results here.
Why test for mould?
We are living in a mould epidemic in the UK with up to 27% of homes impacted by mould. This poses serious health risks, impacting individuals respiratory system, skin, eyes, mental well-being, and in some cases leading to life-threatening conditions.
The main issue is that mould thrives in hidden areas such as wall cavities, air conditioning systems, and insulation, making it difficult to detect with the naked eye. That’s where we come in. Our home mould testing kits will help you identify the hidden dangers so that you can take steps to protect your family.
What is Untold Mould?
At Untold Mould, we want to provide you with the tools to know about the mould that’s in your home, as well as how your air quality is. Our home mould test kit will allow you to easily test for mould at home, enabling you to make decisions about your indoor air quality, allowing you to make vital changes.
Your healthier home starts here.
Testing for mould and knowing what invisible dangers are in your home will help to educate you on how to ensure a healthier home environment. Our home mould testing kits are easy to use, and you’ll receive your results quickly.

An Interview with Dr Peter Cook
“Mould is a fungus that releases a huge number of microscopic spores. The real concern revolves around how many of those spores we end up breathing indoors. We as humans live in warm homes which are perfect environments for harbouring mould.”